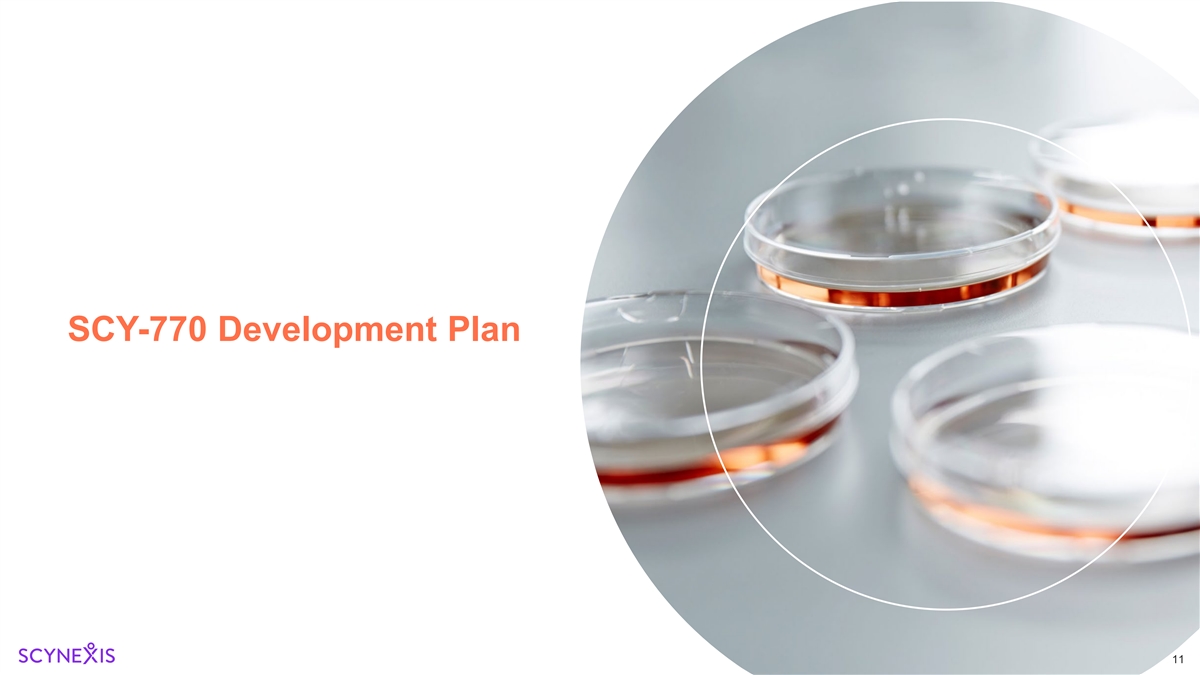

Exhibit 99.1 Advancing innovative solutions for severe rare diseases Corporate Deck March 2026

Legal Disclaimers This presentation has been prepared by SCYNEXIS, Inc. (the “Company”) solely for informational purposes. This presentation contains, and our officers and representatives may from time to time make, “forward-looking statements” within the meaning of applicable securities laws and are prospective in nature, including, but not limited to, statements regarding the Company’s business strategies and goals, plans and prospects, market size, potential revenue, growth opportunities, and current and future products and product candidates. Such statements include, but are not limited to: the clinical development of SCY-770, SCY-247 and other potential product candidates, including anticipated study designs, costs, timelines, and the expected data and efficacy readouts from the planned Phase 2 study; the anticipated regulatory pathway and milestones for SCY-770 and related financial obligations; the anticipated commercial and therapeutic benefits of SCY-770, SCY-247 and other potential product candidates; the clinical development of SCY-247, including results from the intravenous Phase 1 study and the pursuit of funding and partnering opportunities thereof; the timing of future milestones and amount of royalties from the BREXAFEMME license with GSK; the estimated cash runway, the total proceeds raised in connection with the financing; the timing of the closing of the financing and the satisfaction of customary closing conditions; and the anticipated use of proceeds from the financing and related required filings and approvals. These forward-looking statements are subject to risks and uncertainties that could cause actual results to differ materially from those described in the forward-looking statements. These risks and uncertainties include, but are not limited to, risks and uncertainties discussed in the Company’s most recent reports filed with the SEC, including under the caption “Risk Factors” in the Company’s Annual Report on Form 10-K for the year ended December 31, 2025, filed with the U.S. Securities and Exchange Commission (the “SEC”) on March 4, 2026, and in subsequent reports and disclosure documents we have filed and may file with the SEC. Readers are cautioned not to place undue reliance on any of these forward-looking statements. The Company undertakes no obligation to update any of these forward-looking statements to reflect events or circumstances after the date of this Presentation, or to reflect actual outcomes. The data included in this presentation may be subject to change following the availability of additional data or following a more comprehensive review of the data. These statements are based upon the current expectations and beliefs of management and are not guarantees of future performance. This presentation concerns study drugs that are under clinical investigation, and which have not yet been approved by the U.S. Food and Drug Administration or other applicable regulatory agencies. They are currently limited by applicable laws to investigational use, and no representation is made as to their safety or effectiveness for the purposes for which they are being investigated. This presentation also uses estimates and other statistical data made by independent parties and us, relating to the data and analysis about our industry. The data involves a number of assumptions and limitations, and you are cautioned not to give undue weight to such estimates. In addition, projections, assumptions and estimates of our future performance and the future performance of the markets in which we operate are necessarily subject to a high degree of uncertainty and risk. The trademarks included in this presentation are the property of the owners thereof and are used for reference purposes only. 2

AGENDA and SPEAKERS David Angulo, M.D. President and Chief Executive Officer • Corporate Update and Strategic Asset Acquisition Jeremy Duffield, MD, PhD • ADPKD & SCY-770: Disease Landscape Consultant - Expertise in ADPKD and Scientific Rationale Rossana Ferrara-Pontoriero, PhD VP, Business Development & Alliance Management • ADPKD: Market Landscape & Therapeutic Opportunity Ivor Macleod Chief Financial Officer • Financial Update & Outlook 3

SCYNEXIS: Innovation-Driven Focus on Severe Rare Diseases Optionality & Upside from Strategic Asset Acquisition Successful $40M Financing Antifungal Assets SCY-247 SCY-770 for Autosomal Dominant Raised $40M in PIPE financing, • Oral Phase 1 completed Polycystic Kidney Disease extending our cash runway to mid • IV Phase1 results anticipated in (ADPKD), a multi-billion-dollar 2029 giving us optimal flexibility to Q3 2026 market with significant unmet need execute our strategy • Actively seeking non-dilutive • Phase 2 initiation anticipated in funding Q4 2026 • Early efficacy readout GSK-BREXAFEMME partnership expected in 2H 2027 with has potential to deliver up to $146M study completion in 2H in sales milestones + royalties 2028 Experienced Leadership with Proven Success in Drug Development, Regulatory Approvals and Assets Monetization 4

Clinical Stage Asset Acquisition in ADPKD Area of high unmet need and significant commercial opportunity • Jynarque (tolvaptan), the only approved treatment, reached ~$1.5B US sales in 2024 despite significant safety and tolerability limitations SCY-770 Significant interest from pharma and investor community a novel highly selective, direct • Novartis/Regulus acquisition: ~$1.7B total deal/$800M upfront AMP-activated protein kinase • Renasant BIO: ~$54.5M in seed financing from blue-chip investors (AMPK) activator – potential • PYC therapeutics: ~$525M financing, lead asset in ADPKD “Pipeline-in-a-Product” Acquired Global Rights from Poxel, a French Public Biotech o AMPK is involved in multiple diseases, including ADPKD, Key terms of asset acquisition include: adrenoleukodystrophy (ALD) and • $8M upfront other metabolic conditions • $8M in development milestones o $2M upon initiation of Phase 2 o $6M upon initiation of Phase 3 • Up to $180M in total commercial milestones, of which $125M is triggered by annual net sales ≥ $1B • No royalties 5

SCY-770: Well-Characterized, Phase 2 - Ready AMPK Activator • Solid scientific support for AMPK role in ADPKD Novel Mechanism: Direct • Compelling pre-clinical pharmacology package supportive of efficacy AMPK Activator • Evidence of target engagement and PK/PD correlation in a Phase 2a study (NAFLD) • 273 individuals exposed in 8 clinical trials (seven Phase 1 and one Phase 2) Favorable safety profile and 14 o SAD, MAD, Food Effect, DDIs, C-ADME, Ph1b PK/PD & Ph2a in NAFLD well-characterized PK • Non-clinical program supports long-term use • Small-molecule, well characterized DS and DP manufacturing process Oral formulation with robust • Available supplies to enable planned Phase 2 study CMC process and stability • Single Phase 3 study required for approval Clear regulatory path and o Well-defined endpoints for development/approval including an FDA-endorsed surrogate endpoint (TKV) for accelerated approval IP protection up to 2042 • Granted Orphan designation; IND-opened (for NAFLD) AMP-Activated Protein Kinase (AMPK), Pharmacokinetics/Pharmacodynamics (PK/PD), Nonalcoholic Fatty Liver Disease (NAFLD), Single Ascending Dose (SAD), Multiple Ascending Dose (MAD), Drug- Drug Interactions (DDIs), Absorption, Distribution, Metabolism, and Excretion (ADME) Drug Substance (DS), Drug Product (DP), Total Kidney Volume (TKV) 6

ADPKD & SCY-770: Disease Landscape and Scientific Rationale 7

Autosomal Dominant Polycystic Kidney Disease (ADPKD) 1 U.S. Prevalence: ~140,000 patients ADPKD is a genetic disease caused by mutations of the PKD1 or PKD2 genes which encode polycystin complex 1 (PC1) or polycystin complex 2 (PC2) proteins, critical for normal tubular epithelial cell function Patients develop fluid-filled cysts in their kidneys that progressively impair their kidney function o >50% reaching end-stage renal failure in their 60s requiring renal replacement therapies (e.g., dialysis or transplant) Treatment modalities: o No currently available therapies that address the underlying cause of the disease o Disease-modifying therapies aim to delay progression to end-stage renal failure and Kidney Disease: Improving Global Outcomes (KDIGO) ADPKD Work Group. KDIGO 2025 Clinical Practice Guideline for the Evaluation, improve QOL Management, and Treatment of Autosomal Dominant Polycystic Kidney Disease (ADPKD). Kidney Int. 2025 Feb;107(2S):S1-S239. 1. Willey C, et.al. Analysis of Nationwide Data to Determine the Incidence and Diagnosed Prevalence of Autosomal Dominant Polycystic Kidney Disease in the USA: 2013-2015. Kidney Dis (Basel). 2019 Mar;5(2):107-117; 2. Barnawi RA, et al. Is the light at the end of the tunnel nigh? A review of ADPKD burden of disease and tolvaptan as a new treatment. Int J Nephrol Renovasc Dis. 2018 Feb 1;11:53-67. 8

AMPK is Involved in Multiple Pathophysiological Aspects of ADPKD AMPK is a metabolic regulator of cellular energy homeostasis that increases glucose and fatty acid uptake and oxidation when cellular energy is low. It can be activated by several physiological and pharmacological mechanisms • There are 12 versions of AMPK (isoforms), each can have different tissue localizations, and different functions under different conditions Physiological activation via upstream Potent and selective AMPK activator expected to kinases (LKB1 and CaMKK) provide clinically meaningful beneficial effect in ADPKD Activation via ↑ AMP (e.g., metformin - resulting from ↓ ATP production ) Direct allosteric Activators (e.g., SCY 770) 1 Effects of AMPK activation in tubular epithelial cyst cells : ↓ mTOR pathway, suppressing cell proliferation/cyst growth ↓ CFTR-mediated cyst fluid secretion ↓ cAMP suppressing cell proliferation/fluid secretion pathway for tolvaptan’s effect in ADPKD (via V2 antagonism) ↓ Aerobic glycolysis (Warburg effect)→ ↓ cell proliferation/cyst growth ↓ Cyst inflammation and fibrosis 1. Caplan MJ (2022) AMPK and Polycystic Kidney Disease Drug Development: An Interesting Off-Target Target. Front. Med. 9:753418. Mechanistic target of rapamycin (mTOR), Cystic fibrosis transmembrane conductance regulator (CFTR) chloride channel 9

SCY-770 – Demonstrated Robust in vivo Effects in ADPKD Mice Improved survival and renal function Tamoxifen-inducible kidney epithelium–specific Pkd1 deletion (Ksp-TamCre x Pkd1Lox), mice sacrificed when blood urea level was ≥ 20mM (ESRD) and study was terminated when 50% of control mice reached this threshold. n=10 Wild Type n=22 ADPKD control n=22 ADPKD PXL770 90% of ADPKD-SCY-770 (previously PXL770)treated mice survived when threshold of 50% death in ADPKD-control mice was reached (D62) with overall improved renal function (blood urea), similar to wild type mice. Dagorn PG, et al.. A novel direct adenosine monophosphate kinase activator ameliorates disease progression in preclinical models of Autosomal Dominant Polycystic Kidney Disease. Kidney Int. 2023 10 May;103(5):917-929. End Stage Renal Disease (ERDS), Kidney Weight (KW), Body Weight (BW)
SCY-770 Development Plan 11

SCY-770 Illustrative Path Forward 1 Potential accelerated approval based on surrogate endpoint (htTKV) Phase 1* Phase 2 POC EoP2 Phase 3 16-week htTKV FDA inflection point 12-months 24-month htTKV eGFR NDA sNDA htTKV = measures the kidney volume changes via MRI eGFR = measures the kidney function changes Phase 1* (exposure and food effect at doses intended for Phase 2) Accelerated Full FDA FDA Approval Other development activities may include: Approval CMC optimization, scale up and registration batches, additional Phase 1 studies, additional non-clinical assessments 2026 2027 2028 2029 2030 2031 1. TKV an acceptable surrogate endpoint for accelerated approval path in PKD. https://www.fda.gov/drugs/development-resources/table-surrogate-endpoints-were-basis-drug-approval-or-licensure 12

SCY-770 Planned Phase 2 Study Design in ADPKD Objective: provide clinical evidence of SCY-770 magnitude of effect in ADPKD patients Cohorts Anticipated timelines: Analysis 2026 Q4 Study Initiation 2027 Randomized Double-Blind Q2/Q3 Enrollment completion Open Label H2 POC 16-week htTKV data 2028 SCY-770 - n=20 – Dose 1 H2 Final data set Screening Run Follow SCY-770 - n=20 – Dose 2 SCY-770 selected dose (n=50) in up Placebo - n=10 1 TKV 4w 2w 16w POC 32 w 2w Kidney Volume: htTKV Key eligibility criteria Endpoints • Male or female ADPKD subjects, 18 to 55 yo Efficacy: • Kidney volume: htTKV (every 16 weeks) • Class 1C, 1D, or 1E Mayo Imaging • Kidney function: eGFR (every 16 weeks) Classification of ADPKD (Rapid Other efficacy measurements: progressors) • Cyst number and volume, non-cyst kidney volume, mGFR, UACR, additional ADPKD and AMPK biomarkers • eGFR ≥ 45 and ≤ 90 mL/min/1.73m² Safety, Tolerability and PK • No Tolvaptan intake Height-adjusted Total Kidney Volume (htTKV), Estimated glomerular filtration rate (eGFR), Measured glomerular filtration rate (mGFR), Urine Albumin-to-Creatinine Ratio (UACR) 13

ADPKD: Market Landscape & Therapeutic Opportunity 14

ADPKD is an Orphan Indication Associated with Significant Clinical and Economic Burden 1 2 U.S. prevalence of ~140,000 patients with ~6,000 new cases diagnosed / year 1,2 1 Clinical Burden Economic Burden Kidney Impact ~$7.3B-$9.8B in incremental costs equivalent to ~$52k-$68k per individual with ADPKD o Kidney pain, gross hematuria, and urinary tract infection o Significant direct healthcare cost (~$5.7B) o More than 50% of patients reach end-stage renal disease requiring due to dialysis and renal replacement therapy renal replacement therapies Mortality 1 o 1.8 to 5.4-fold higher risk of all-cause mortality in 35 years and older QOL Impact Underserved market with only one approved treatment and significant o Limitations in physical activity, work productivity, and social interaction opportunity for new therapies o Decreased ability to work, the negative effects of a diagnosis on insurability, and the costs of medical care 1. Cloutier M, et.al. The societal economic burden of autosomal dominant polycystic kidney disease in the United States. BMC Health Serv Res. 2020 Feb 18;20(1):126.; 2. Oberdhan D, et.al. Patient- 15 Reported Outcomes Measures, Polycystic Kidney Disease Burden, and Outcomes in Autosomal Dominant Polycystic Kidney Disease. Kidney Med. 2023 Nov 27;6(1):100755.

Jynarque, the Only Approved Product for ADPKD Reached Blockbuster Status Despite Limited Uptake 1 In 2024, Otsuka reported ~$1.5B despite limited penetration (<10%*) of total diagnosed population 2 Annual Jynarque U.S. Sales ($M) • Black box warning due to the potential for fatal $1,528 3 liver injury and failure requiring transplantation • REMS program with ongoing liver monitoring in $1,237 3 patients o Biweekly, monthly, quarterly liver function tests $1,016 • Disease modifying, only used in patients with $803 rapidly progressing ADPKD $646 • High treatment burden due to polyuria leading to discontinuation $450 o Patients must endure high urine output 4 (6+ L/day) and urination at night 5 • 2025 WAC price of $192K (U.S.) • Lupin Pharma launched generic in 2025 2019 2020 2021 2022 2023 2024 *Based on US figures SCY-770 targets cyst growth and disease progression through a broadly applicable MOA, with potential for improved efficacy and safety 16 1. Otsuka Integrated Report 2024; 2. Evaluate Pharma ; 3. Jynarque Prescribing Information; 4. Clin Exp Nephrol. 2017 June ; 21(3): 375–382; 5. Counterforce Health Team Jynarque (Oct 2025)

Financial Update & Outlook 17

Financial Outlook SCYNEXIS is well-capitalized to support execution of development plans • Cash runway into mid-2029 • ~$56M in cash, cash equivalents and investments as of 12/31/2025 • ~$40M of gross proceeds from recent PIPE • No debt Potential to receive up to $146M in Pursuing non-dilutive financing BREXAFEMME sales milestones, opportunities to further support the plus low-to-mid-single digit net development of SCY-247 royalties from GSK 18

SCYNEXIS Pipeline Lead program focused on ADPKD Preclinical Phase 1 Phase 2 Phase 3 Status • Phase 1 confirmatory study planned in Q2 2026 ADPKD Oral • Phase 2 POC initial readout expected in H2 2027 SCY-770 ALD and other Oral • Phase 2 ready relevant diseases • Completed Phase 1 Oral Treatment of Invasive SAD/MAD Candidiasis and Prophylaxis of SCY-247 invasive fungal • Phase 1 readout expected in diseases IV Q3 2026 Treatment of resistant Development up to IND funded by Antifungal fungi with novel Oral/IV NIH via a CTER grant of ~$7M analogs structural analogs Potential for up to ~$146 million in sales milestones plus net royalties in the VVC and Approved ® low-to-mid-single digits upon BREXAFEMME relaunch by GSK* Recurrent VVC Partnered with *GlaxoSmithKline Intellectual Property (No. 3) Limited 19

SCYNEXIS: Anchored by Strong Fundamentals Combining key elements to create value for all stakeholders Committed to Innovative Science: Clear Go-Forward Strategy Achievable Targeting Severe, Rare Conditions with Existing Resources • SCY-770: Clinical stage, novel highly selective • Generate early efficacy readout from Phase 2 AMPK activator with promising MOA study of SCY-770 by H2 2027 st • 1 indication targeting ADPKD, a rare • Experienced management team with proven condition with clear unmet need, limited track record of drug approvals and asset treatment options and anticipated large monetization commercial opportunity nd • SCY-247: Clinical stage, 2 generation anti- fungal designed to treat and prevent severe fungal diseases 20